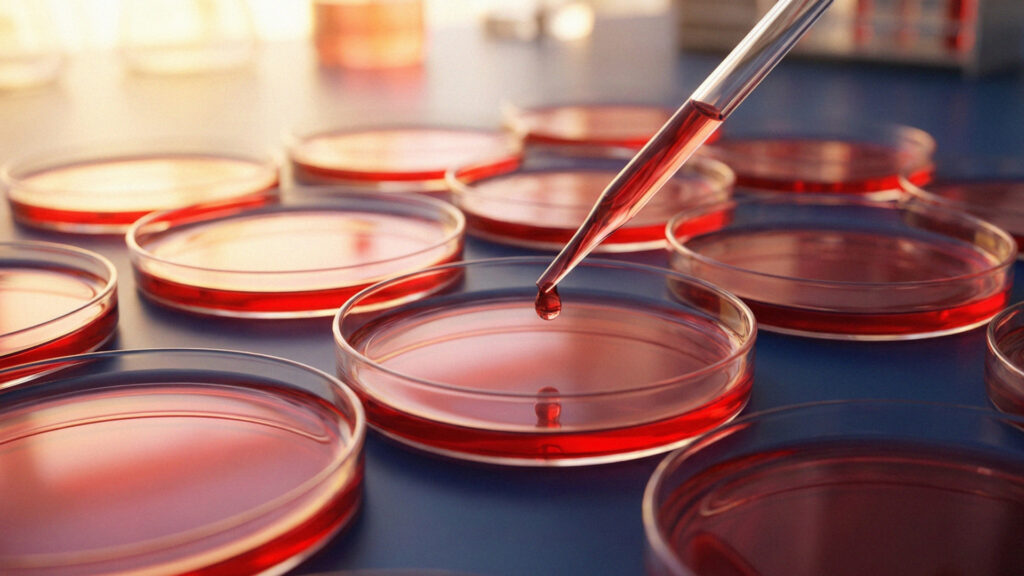
Bunkové kultúry

Váš špecialista pre laboratórium
Od roku 1995 sme partnerom pre Vašu laboratórnu prax. Dodávame výrobky renomovaných značiek, ktoré pokrývajú celé spektrum práce v biologickom a biochemickom laboratóriu.
Kontaktujte násNáš tím je tu pre vás.
Kontaktujte nás pre odbornú pomoc a poradenstvo

RNDr. Michaela Osadská, PhD.
Obchodný manažér

RNDr. Zuzana Boleková Valovičová, PhD.
Obchodný manažér
Naše produkty
Preskúmajte široký sortiment nášho produktového portfólia


Reagencie

Laboratórne plasty
Bunkové kultúry

Protilátky

Prístroje a pomôcky
Naše služby
Certifikovaní partneri, odborné poradenstvo, návrh riešení, servis produktov a školenia.
Komplexné odborné poradenstvo a konzultácie
Návrh experimentov a optimalizácia protokolov
Zabezpečenie servisu a kalibrácie prístrojov
Sekvenačné a analytické služby (outsourcing)

















